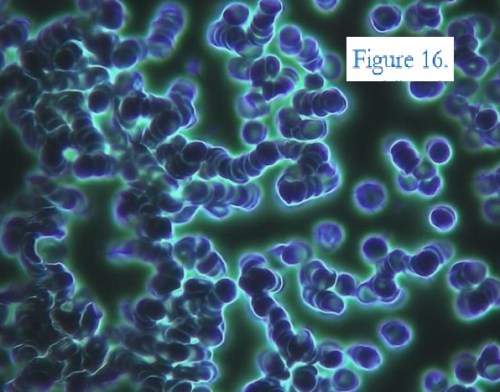

A recently published report shows the results of an Italian study in which researchers examined the blood of 1,006 individuals (about 50/50 male/female) who were symptomatic post-vaxxx. Only 58 subjects had normal post-jab blood.
The published paper includes photos of anomalies from 4 of the subjects which illustrate the range and types of the anomalies in the blood of 948 subjects.

Figure 1: Left (a) shows normal blood before inoculation. Right (b) shows the same person’s blood one month after the first dose of Pfizer mRNA vaxxx. Note that the red blood cells in (b) are no longer spherical and are clumping. (40x mag)

Figure 2: This photo shows crystalline features resembling butterfly wings. The study includes a number of other photos of crystalline structures of different shapes.

Figure 4: This 120x mag image shows a typical, fibrous, tubular, self-aggregating structure. These structures can merge, reaching dimensions ten times their original size. Figure 5 shows more of the same. (CtH: This looks like what the embalmers are finding. See “Clots”, linked below.)

Figure 6: This 120x mag image shows a mass of particles collecting into a ball that is approximately 114 micrometers (μm) across, too large to fit through arterioles (30 μm), venules (20 μm), or capillaries (8 μm).

Figure 7: 40x mag photos of (a) pre-jab and (b) post-jab blood clearly shows how the vaxxx caused the red blood cells to change shape and clump together. Figure 8 (a) and 9 (a) show more of the same, as well as evidence of hemolysis (destruction or dissolution of red blood cells).

Figures 8 (b) and 9 (b): These images (120x mag) show foreign, crystallized, tubular structures.

Figure 10 (b): This image, at 120x magnification, shows a very large clump of something that was even larger (329 μm by 137 μm) than the one in Figure 6.
Figure 16: This image, at 40x mag, shows red blood stacking themselves. This is caused by abnormal proteins in the blood that decrease the normal, healthy distance red cells maintain between each other.
Excerpts from the researchers’ conclusions: “With the hematological pictures we have presented here it is reasonable to expect reactivation of oncological disease along with blood circulation disorders. … The sudden transition, usually at the time of a second mRNA injection, from a state of perfect normalcy to a pathological one … is unprecedented. Such phenomena have never been seen before after any ‘vaccination’ of the past.”
The study was published in International Journal of Vaccine Theory, Practice, and Research (August 2022) and appears in full @ https://ijvtpr.com/index.php/IJVTPR/article/view/47/86.
Other sources:






